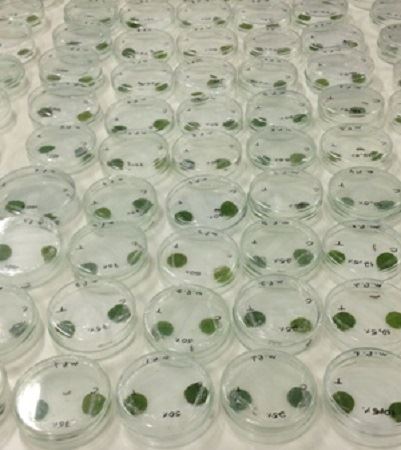

Pesquisa com óleo de eucalipto para combater mosca-do-chifre - Foto: Divulgação / Fundect
Para resolver essa problemática, há seis anos o laboratório de pesquisa em entomologia da Universidade Anhanguera Uniderp trabalha na produção de óleo de eucalipto para servir de repelente contra esse vetor. O engenheiro agrônomo Silvio Fávero, coordenador da pesquisa, destacou que esse mesmo produto já foi identificado como sendo eficaz contra pragas agrícolas. "Já temos resultados positivos na utilização do óleo de eucalipto no combate às pragas agrícolas como a lagarta do cartucho e o percevejo marrom da soja, além de ser eficaz em vetores como o barbeiro e a mosca doméstica”, explicou o engenheiro.
O óleo de eucalipto, por ser natural, tem menor impacto nocivo aos animais. Ao mesmo tempo, a pesquisa identificou que ele age diretamente no sistema nervoso do inseto nos sítios octopaminérgicos. "Esta solução é menos tóxica para o homem e fatal para a mosca", garantiu o pesquisador. Os testes vem sendo feitos em laboratório com três diferentes espécies de eucalipto. Segundo os pesquisadores, é preciso verificar qual destes apresenta a concentração adequada para combater o mosquito.
A Fundação de Apoio ao Desenvolvimento do Ensino, Ciência e Tecnologia do Estado de Mato Grosso do Sul (Fundect) ajuda no financiamento do trabalho, que é desenvolvido entre mestrandos e doutorandos do curso de Meio Ambiente e Desenvolvimento Regional.
Somente no primeiro trimestre deste ano, a exportação da celulose acumulou alta de 22% em valores e 19,43% em volume (comparado com mesmo período de 2015). No campo, o plantio da espécie continua atraindo produtores de outras culturas, principalmente da pecuária, mesmo diante da crise econômica e da alta do dólar, fatos que mantiveram os preços da madeira estagnados no mercado interno como reflexo do aumento da oferta.
As informações são do Correio do Estado.






